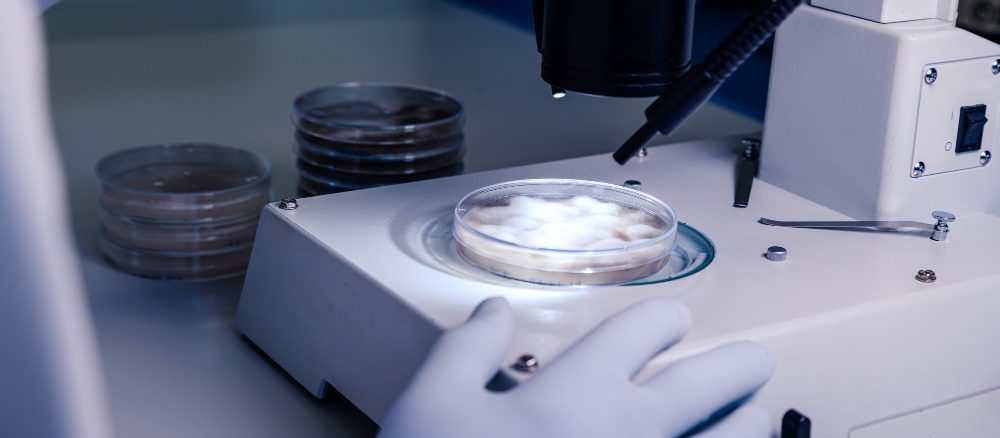

في ظل التقدم العلمي السريع في مجال علاج تأخر الإنجاب، أصبحت خيارات المساعدة على الحمل متعددة. من بين هذه الخيارات، يبرز كل من الحقن المجهري والتلقيح الصناعي كحلول فعالة لكثير من الأزواج. لكن يبقى السؤال الأهم: ما الفرق بين هاتين الطريقتين؟ وأي منهما أنسب لكِ حسب حالتك؟
أولًا: ما هو التلقيح الصناعي (IUI)؟
التلقيح الصناعي هو إجراء بسيط وغير جراحي يتم فيه إدخال الحيوانات المنوية مباشرة إلى رحم الزوجة أثناء فترة التبويض، باستخدام قسطرة رفيعة.
هذا الإجراء يُستخدم عادة في الحالات التالية:
ضعف بسيط في حركة أو عدد الحيوانات المنوية
مشاكل في التبويض
وجود سبب غير مفسر لتأخر الحمل
حالات العقم الخفيف عند النساء
نسبة النجاح: تتراوح بين 10% إلى 20% لكل دورة، وتزداد بوجود تحفيز دوائي للمبايض.
ثانيًا: ما هو الحقن المجهري (ICSI)؟
الحقن المجهري هو أحد تقنيات أطفال الأنابيب، ويعتمد على تلقيح بويضة واحدة بحيوان منوي واحد تحت المجهر في المختبر، ثم يتم نقل الجنين إلى الرحم. يُستخدم في الحالات الأكثر تعقيدًا، مثل:
ضعف شديد في الحيوانات المنوية
انسداد قنوات فالوب
فشل التلقيح الصناعي المتكرر
تقدم عمر المرأة
تأخر حمل غير مفسر بعد محاولات كثيرة
نسبة النجاح: تتراوح بين 40% إلى 60% في أغلب الحالات، وتختلف حسب عمر المرأة وجودة الأجنة.
أي الطريقتين أنسب لحالتك؟
يُحدد الطبيب الطريقة المناسبة بعد تقييم شامل للحالة، يشمل:
تحليل السائل المنوي
فحوصات المبيض وقنوات فالوب
تقييم التبويض
الفحوصات الهرمونية
في الحالات البسيطة، غالبًا ما يبدأ الطبيب بالتلقيح الصناعي، أما في الحالات المعقدة فيكون الحقن المجهري هو الخيار الأنسب.
الخاتمة
الاختيار بين الحقن المجهري والتلقيح الصناعي لا يجب أن يتم بناءً على التكلفة فقط، بل يجب أن يُبنى على تقييم طبي دقيق. استشيري طبيبك المختص لتحديد الإجراء الأنسب لحالتك، فكل حالة لها خصوصيتها، والقرار الصحيح هو ما يقودك إلى حلم الأمومة.